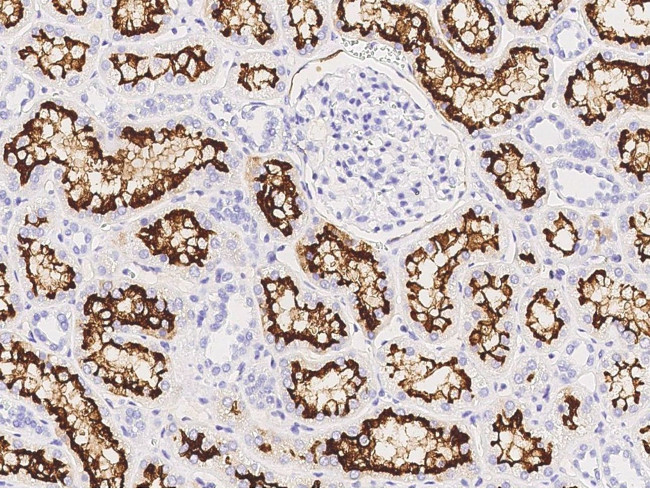
ACE2 Antibody in Immunohistochemistry (Paraffin) (IHC (P))

Search
Invitrogen
ACE2 Polyclonal Antibody
{{$productOrderCtrl.translations['antibody.pdp.commerceCard.promotion.promotions']}}
{{$productOrderCtrl.translations['antibody.pdp.commerceCard.promotion.viewpromo']}}
{{$productOrderCtrl.translations['antibody.pdp.commerceCard.promotion.promocode']}}: {{promo.promoCode}} {{promo.promoTitle}} {{promo.promoDescription}}. {{$productOrderCtrl.translations['antibody.pdp.commerceCard.promotion.learnmore']}}
产品信息
PA5-80297
宿主/亚型
分类
类型
抗原
偶联物
形式
保存条件
运输条件
RRID
产品详细信息
This product is preservative free. It is recommended to add sodium azide to avoid contamination (final concentration 0.05%-0.1%).
This antibody has specificity for Human ACE2/Angiotensin-Converting Enzyme 2.
靶标信息
Angiotensin-converting enzyme 2 (ACE2) plays a central role in vascular, renal, and myocardial physiology. In contrast to its homolog ACE, ACE2 expression is restricted to heart, kidney, and testis. Recently. ACE2 has also been shown to be a functional receptor of the SARS coronavirus. The normal function of ACE2 is to convert the inactive vasoconstrictor angiotensin I (AngI) to Ang1-9 and the active form AngII to Ang1-7, unlike ACE, which converts AngI to AngII. While the role of these vasoactive peptides is not well understood, lack of ACE2 expression in ace2-/ace2- mice leads to severely reduced cardiac contractility, indicating its importance in regulating heart function.
仅用于科研。不用于诊断过程。未经明确授权不得转售。